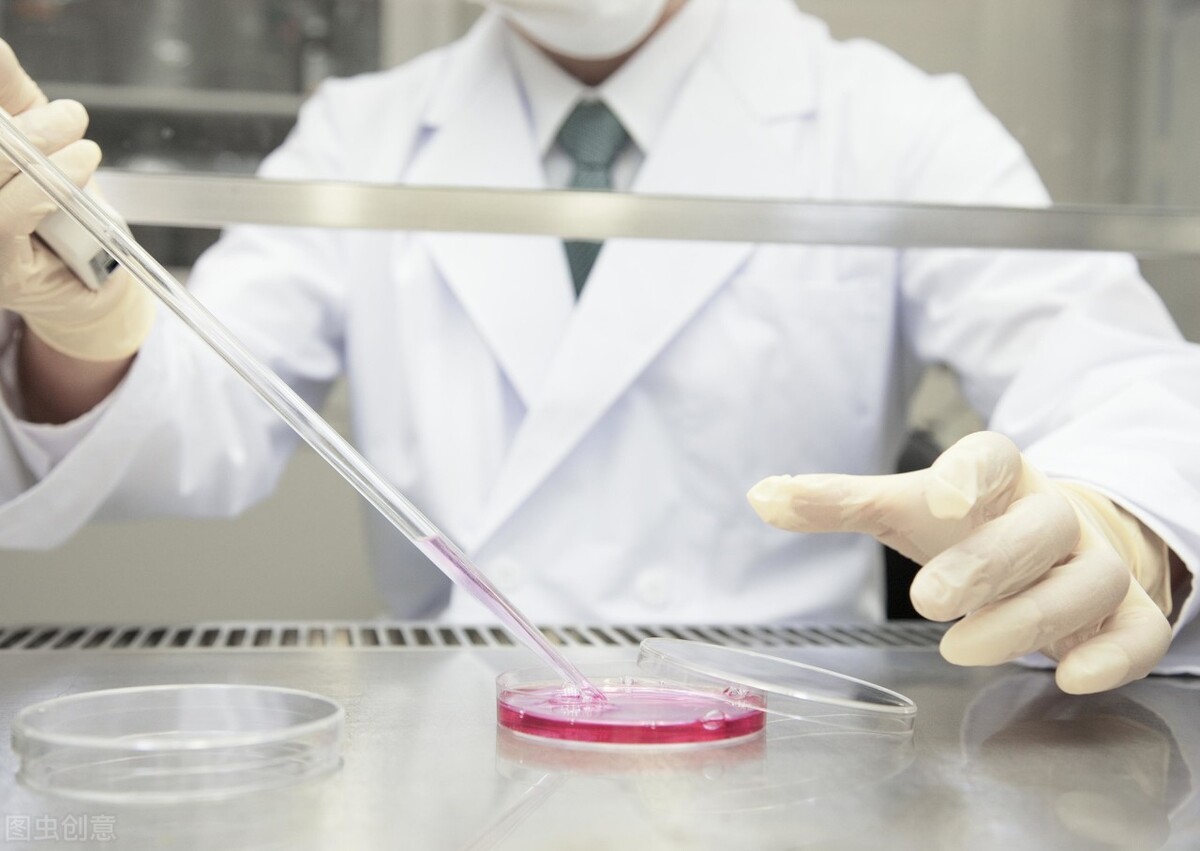

一、知识面要广,这样,你听也听得懂,看也看得明白,要说也说得清楚
身边不乏“上知天文下知地理”的朋友,这些人并不是说全部都知道,但是涉猎很广,而且不是满口胡言,是恰到好处的和对方对话。别人聊事业,他能跟着聊事业。别人聊感情,他也能跟着聊感情。别人聊房价股票,他也能跟着说几句。
总之,他能让人产生一种感觉,知识面广。
还能让人产生一种感觉,这人在认真听我说话。这样的人,也的确在知识面上下了功夫,一方面他自己肯学习,善于学习,博览群书,多有涉猎。另一方面,他因为和很多不同层次不同行业的人接触,在接触的过程中,听多了聊多了,自己也成为了半个专家。这样的万金油朋友,平日里还真少不了,圈子里缺了他,还不好玩。有他在的场合,就一定不会冷场。
二、研究要深入,当你对一件事情或者一个专业乃至是一类人或者一个问题感兴趣,你就要深入研究。
研究要深入,而且相对全面,能有多认真就有多认真,你越认真研究,当你说出来做出来的时候,就越能显示你的专业性。要对自己即将发表的观点和看法负责任,要有这样的小心求证的精神,也是一种工匠精神。
当一个人,在某个细分领域专注的时间足够长,研究的时间足够长,他一定会成为这个行业的专家,至少,他有了专业知识,也就有了一定的话语权。当别人聊到这个领域的时候,他能说出权威的观点,能说出自己经过考证之后的真知灼见,也能说出大家不知道不了解的奇闻异事。
这就很讨人喜欢的了。如果朋友遇到这方面的问题,他们会第一时间想到你。专业是一个人体现价值最好的方式,专业也是一个人身上最好的标签。
当别人觉得你专业的时候,找你帮忙的时候,就是你的价值体现的时候,如果应用在商业上面,你的专业就能为你赚钱,能为你带来行业地位。
当然,我不是倡导一种老学究,我只是想让自己说的每一句话每一件事情听上去不那么轻浮,而是可信一些,接近真相一些。
这样,无论你是在生活中还是职场商场中,你都是那个不可或缺很重要的角色。

三、我们可以听别人的话、看别人的书,但是不能全从照做,要有自己的理解和经历。
这一点很重要,在能力范围内,想去看想去做的事情应该要尽快去做尽量做到。不要被别人定位,更不要自我设限。
我曾经看过一本书,《思考,快与慢》(【美】丹尼尔·卡尼曼 著 胡晓姣 李爱民 何梦莹 译 中信出版社出版),里面有一个很重要的观点:要警惕并避免盲目遵从自己或他人的经验及教训。
我们从一个结果去倒推发生过的事情,是不太好判断过去的事情是对还是错,是合理还是不合理的。
也许对这个结果来说可以判断对错,但是对于学习者来说,盲目遵从过去的经验或者教训,生搬硬套就不对了。
我在自己的读书笔记中这样写道:
“因为发生过的事情无法改变也无法重演,在一堆静止的事件中总是更容易总结出“关联”,而实际上,这些“关联”很大程度上是随机产生的,并不具备代表性,也无规律可言,我们却以此为“认知”,作为判断的依据,去指导后面的行为,甚至去做预测和判断,是不科学的。
固然,如果运气够好,这种“认知”恰好符合某种事情一个阶段内的规律,就有了一定的合理性,但是依然还是有偏见性和局限性。
实际生活中,每一个瞬间都会有千万种变化的可能,即使我们只做一个选择,也未必就会导向我们期待的结果。越是对未来精确的判断,越是不可信。而如果只是泛泛而谈的判断,预测的是趋势,实际上也并无太多参考价值。已知的很多时候是狭隘与谬误,是未知。”

四、执行能力要强,不要拖延
这点很重要,甚至最重要,因为前面三点,差不多可以归类为输入阶段,这个阶段是输出阶段。如果说第一点是广涉猎,第二点是深研究,第三点是辨是非,那么第四点便是重执行。
说起执行力,每个人都知道很重要。但是人人皆有惰性。一个人要成事,在某个行业有点出息,能出人头地,执行力一定强。
那么,如何让自己执行力强呢?其实就是想到之后要去做,明白了一个道理要去践行,实践出真知。道理就这么简单。
苏轼有云:古之成大事者,非有超世之才,亦必有坚韧不拔之志!
这里讲的也是要有执行力,有才华有知识还不行,一定是有坚持执行的意志力,行动力超强。你想想,坚韧不拔的意志,那得是多么强的执行力,屡败屡战,勇于实践,才能成就一番大事业。
其实,我今天讲的,也就是知行合一这么个道理,也是输入和输出这么一个关系。一个人,如果想在社会上有所成就,就必须广涉猎、深研究、辨是非、重执行。能做到这四点,就具备了成事的能力,即便时运不济,也不会差到哪里去。

各位网友大家好,我是喜欢读书写作的纳兰明心,大家对于我的观点有什么看法,欢迎下方留言,我们一起交流成长。





